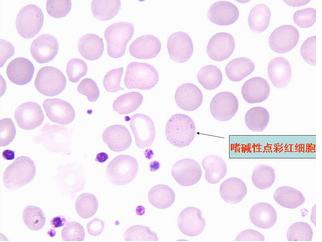
遗传性椭圆形红细胞增多症

椭圆形红细胞图片
遗传性椭圆形红细胞增多症
图片尺寸516x498
见于哪些疾病 ()a,遗传性椭圆性红细胞增多症b,缺铁性贫血c,恶性贫血
图片尺寸253x258
其他人的都是椭圆形而且很漂亮.可是我的就很奇怪很难看.
图片尺寸768x1024
遗传性椭圆形红细胞增多症
图片尺寸1080x1920
遗传性椭圆形红细胞增多症
图片尺寸220x218
图 5 遗传性椭圆红细胞增多症 ② 破碎红细胞(裂红细胞,头盔状细胞,红
图片尺寸358x238
其他人的都是椭圆形而且很漂亮.可是我的就很奇怪很难看.
图片尺寸768x1024
遗传性椭圆形红细胞 增多症
图片尺寸680x510
遗传性椭圆形红细胞 增多症
图片尺寸680x510
遗传性椭圆形红细胞 增多症
图片尺寸680x510
遗传性椭圆形红细胞 增多症
图片尺寸680x510遗传性椭圆形红细胞增多症
图片尺寸322x242
遗传性椭圆形红细胞增多症
图片尺寸200x151
遗传性椭圆形红细胞 增多症
图片尺寸680x510
检验主管技师辅导红细胞形态异常2
图片尺寸366x275
6fl,网织红细胞 (reticulocyte,ret)11.3%,plt 117×109/l.
图片尺寸523x381
遗传性椭圆形红细胞增多症
图片尺寸220x205
临床基本功│红细胞异常知多少
图片尺寸320x240
遗传性椭圆形红细胞增多症
图片尺寸220x157
但这并不妨碍我们对hdn的怀疑,特别是在片子尾部发现球形红细胞
图片尺寸660x735
猜你喜欢:新月形红细胞图片低色素性红细胞图片泪滴状红细胞图片裂红细胞图片棘形红细胞的形态图片靶形红细胞图片口形红细胞图片镰形红细胞图片球形红细胞图片红细胞图片椭圆形图片卡通图片红细胞图片显微镜红细胞图片卡通红细胞巨噬细胞椭圆形图案图片大全椭圆形图片红细胞图片简笔画工作细胞红细胞红细胞结构图红细胞结构简图椭圆形实物图片椭圆形状图片椭圆形图片物品靶形红细胞红细胞手绘图椭圆形图片简单原始红细胞手绘图红细胞形态椭圆形图片大全儿童红细胞壁纸黑暗系头像黑化qq头像情头 魔道祖师持针器组件设计动物园biubiubiu表情包动态门的样式效果图妇科指检泄露dc联名小丑手表女款漆皮单皮鞋1921数字绘画成都地铁六号线地图保密工作绘画作品